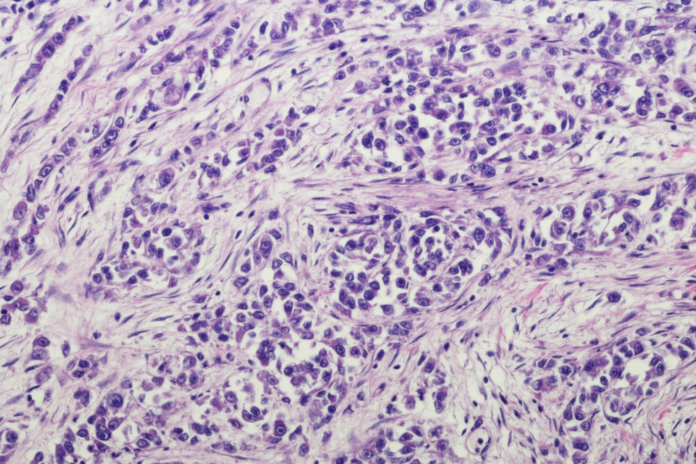

«Establecer los mecanismos rápidos de derivación hacia esos centros especializados como segunda opinión» ha sido el principal objetivo planteado por el presidente de la Comisión de Sanidad del Congreso de los Diputados, Agustín Santos Maraver, durante la celebración de una jornada sobre sarcomas, algo que ha sido apoyado por representantes clínicos y de pacientes.
De esta manera se ha referido Santos Maraver a los centros de expertos y los Centros, Servicios y Unidades de Referencia (CSUR) existentes en España, cuyo acceso por parte de los pacientes de este cáncer es «la cuestión clave» a través de un protocolo de actuación.
Así lo ha expuesto este representante político durante la celebración de la mesa inaugural del encuentro ‘Retos y soluciones para los pacientes con sarcoma en España’, que se ha celebrado, este viernes, 6 de febrero, en la Cámara Baja, organizada por la Asociación de Sarcomas Grupo Asistencial (ASARGA).
«Estamos intentando ver cómo se puede hacer esto», ha continuado Santos Maraver en relación con este protocolo, al tiempo que ha destacado que «el Ministerio de Sanidad, que es el que coordina pero no decide sobre estas cuestiones, tiene que proponer ese protocolo». De hecho, ha recordado que este lo ha elevado «en varias ocasiones», pero «el problema es cómo conseguir que haya ese acuerdo entre todas las comunidades autónomas».
Este representante político lamenta que «no siempre, cuando se da el primer diagnóstico en uno de los centros que no están especializados, hay flexibilidad para aceptar la necesidad de esta segunda opinión». Por tanto, ha resumido que «el problema es que la derivación es complicada».
En este contexto, la doctora Cleofe Romagosa, quien es miembro del CSUR del barcelonés Hospital Universitario Vall dHebrón, ha reclamado que se constituya «una red» para realizar estas derivaciones, para que, con ello, «sea fácil el envío de casos». «No en todas las comunidades autónomas hay centros con volumen suficiente de sarcomas como para tener experiencia clara», ha explicado.
Para apoyar estas afirmaciones, Romagosa ha indicado que, según estudios internacionales, existe «hasta un 40 por ciento de discordancias diagnósticas cuando el diagnóstico lo hace un patólogo especializado o no».
IMPORTANCIA DEL DIAGNÓSTICO PRECOZ
«Invertir en centros de referencia y en centros de expertos en sarcomas» ha sido reclamado por el doctor Eduardo Ortiz, en representación del CSUR del Hospital Universitario La Paz de Madrid, que lo consideraría «justicia sanitaria». «Los pacientes no piden privilegios, piden que su primera cirugía sea correcta, que su diagnóstico sea precoz», algo que «salva vidas y reduce secuelas», ha enfatizado.
Abundando en ello, Ortiz ha puesto de relieve que «la supervivencia y calidad de vida dependen directamente de un diagnóstico precoz». «Es el colmo que el código postal pueda condicionar el diagnóstico», ha insistido.
En este encuentro también ha intervenido el doctor Íñigo San Miguel, quien trabaja en el Complejo Asistencial Universitario de Salamanca, y que ha destacado que «no todo tiene que ser CSUR», ya que «hay grandes centros de expertos que pueden hacer grandes cosas». No obstante, ha indicado que se necesita «tiempo» para que el profesional pueda dedicarse a la formación.
Llevar a cabo un ‘clinical fellowship’ para la especialización en esta u otras materias, «para la Administración, es un año sabático», ha declarado San Miguel, que aboga por «reconocerlo», ya que supone «un valor especial». «Es el colmo que el ‘clinical fellowship’ no esté acreditado y sí un máster que puedes hacer ‘online'», ha expresado, en esta línea, Ortiz, quien ha agregado que existe «falta de cirujanos específicos».
NO EXISTE UN REGISTRO NACIONAL DE PERSONAS CON ESTA ENFERMEDAD
Además, la doctora Gloria Marquina, que es miembro del Grupo Español de Investigación en Sarcoma (GEIS), se ha referido a otro asunto, señalando que, en la actualidad, no existe un registro nacional de sarcomas. «No sabemos cuantos pacientes con sarcoma hay en España», ha confirmado, ante lo que ha destacado el «voluntario» creado por la institución a la que representa, el cual cuenta «con los hospitales que se han querido adherir».
«Se nos pierden un montón de pacientes», ha manifestado Marquina, mientras que la presidenta de ASARGA, María Teresa Deus, ha recordado que, por ello, existe «desigualdad territorial en el acceso a tratamientos» y «retraso en diagnóstico». De hecho, esta última ha dado un paso más, reclamando acceso a ensayos clínicos y subrayando el que debería ser «papel fundamental de los pacientes en la evaluación de medicamentos y en el diseño de las políticas sanitarias».
Precisamente sobre el papel político, Santos Maraver ha reconocido que, según la región, «se han producido diferencias poco explicables, como el número de camas de Unidades de Cuidados Intensivos (UCI) o la inversión por habitante», ante lo que ha sostenido que «la Sanidad tiene que ser pública y universal».
Junto a ello, y abordando inequidades, el presidente de la Comisión de Sanidad del Congreso de los Diputados ha alertado del «crecimiento de la Medicina Privada», ya que este sector «crea una diferenciación de acceso mucho mayor que con las comunidades autónomas y podría crear distorsiones gravísimas».
Todo ha sido abordado en una cita en la que se ha recordado que los sarcomas representan el 1 por ciento de todos los cánceres, englobando más de 150 enfermedades tumorales distintas, la mayor parte de ellas ultra raras. En concreto, en España se dan cada año cerca de 2.700 nuevos casos.